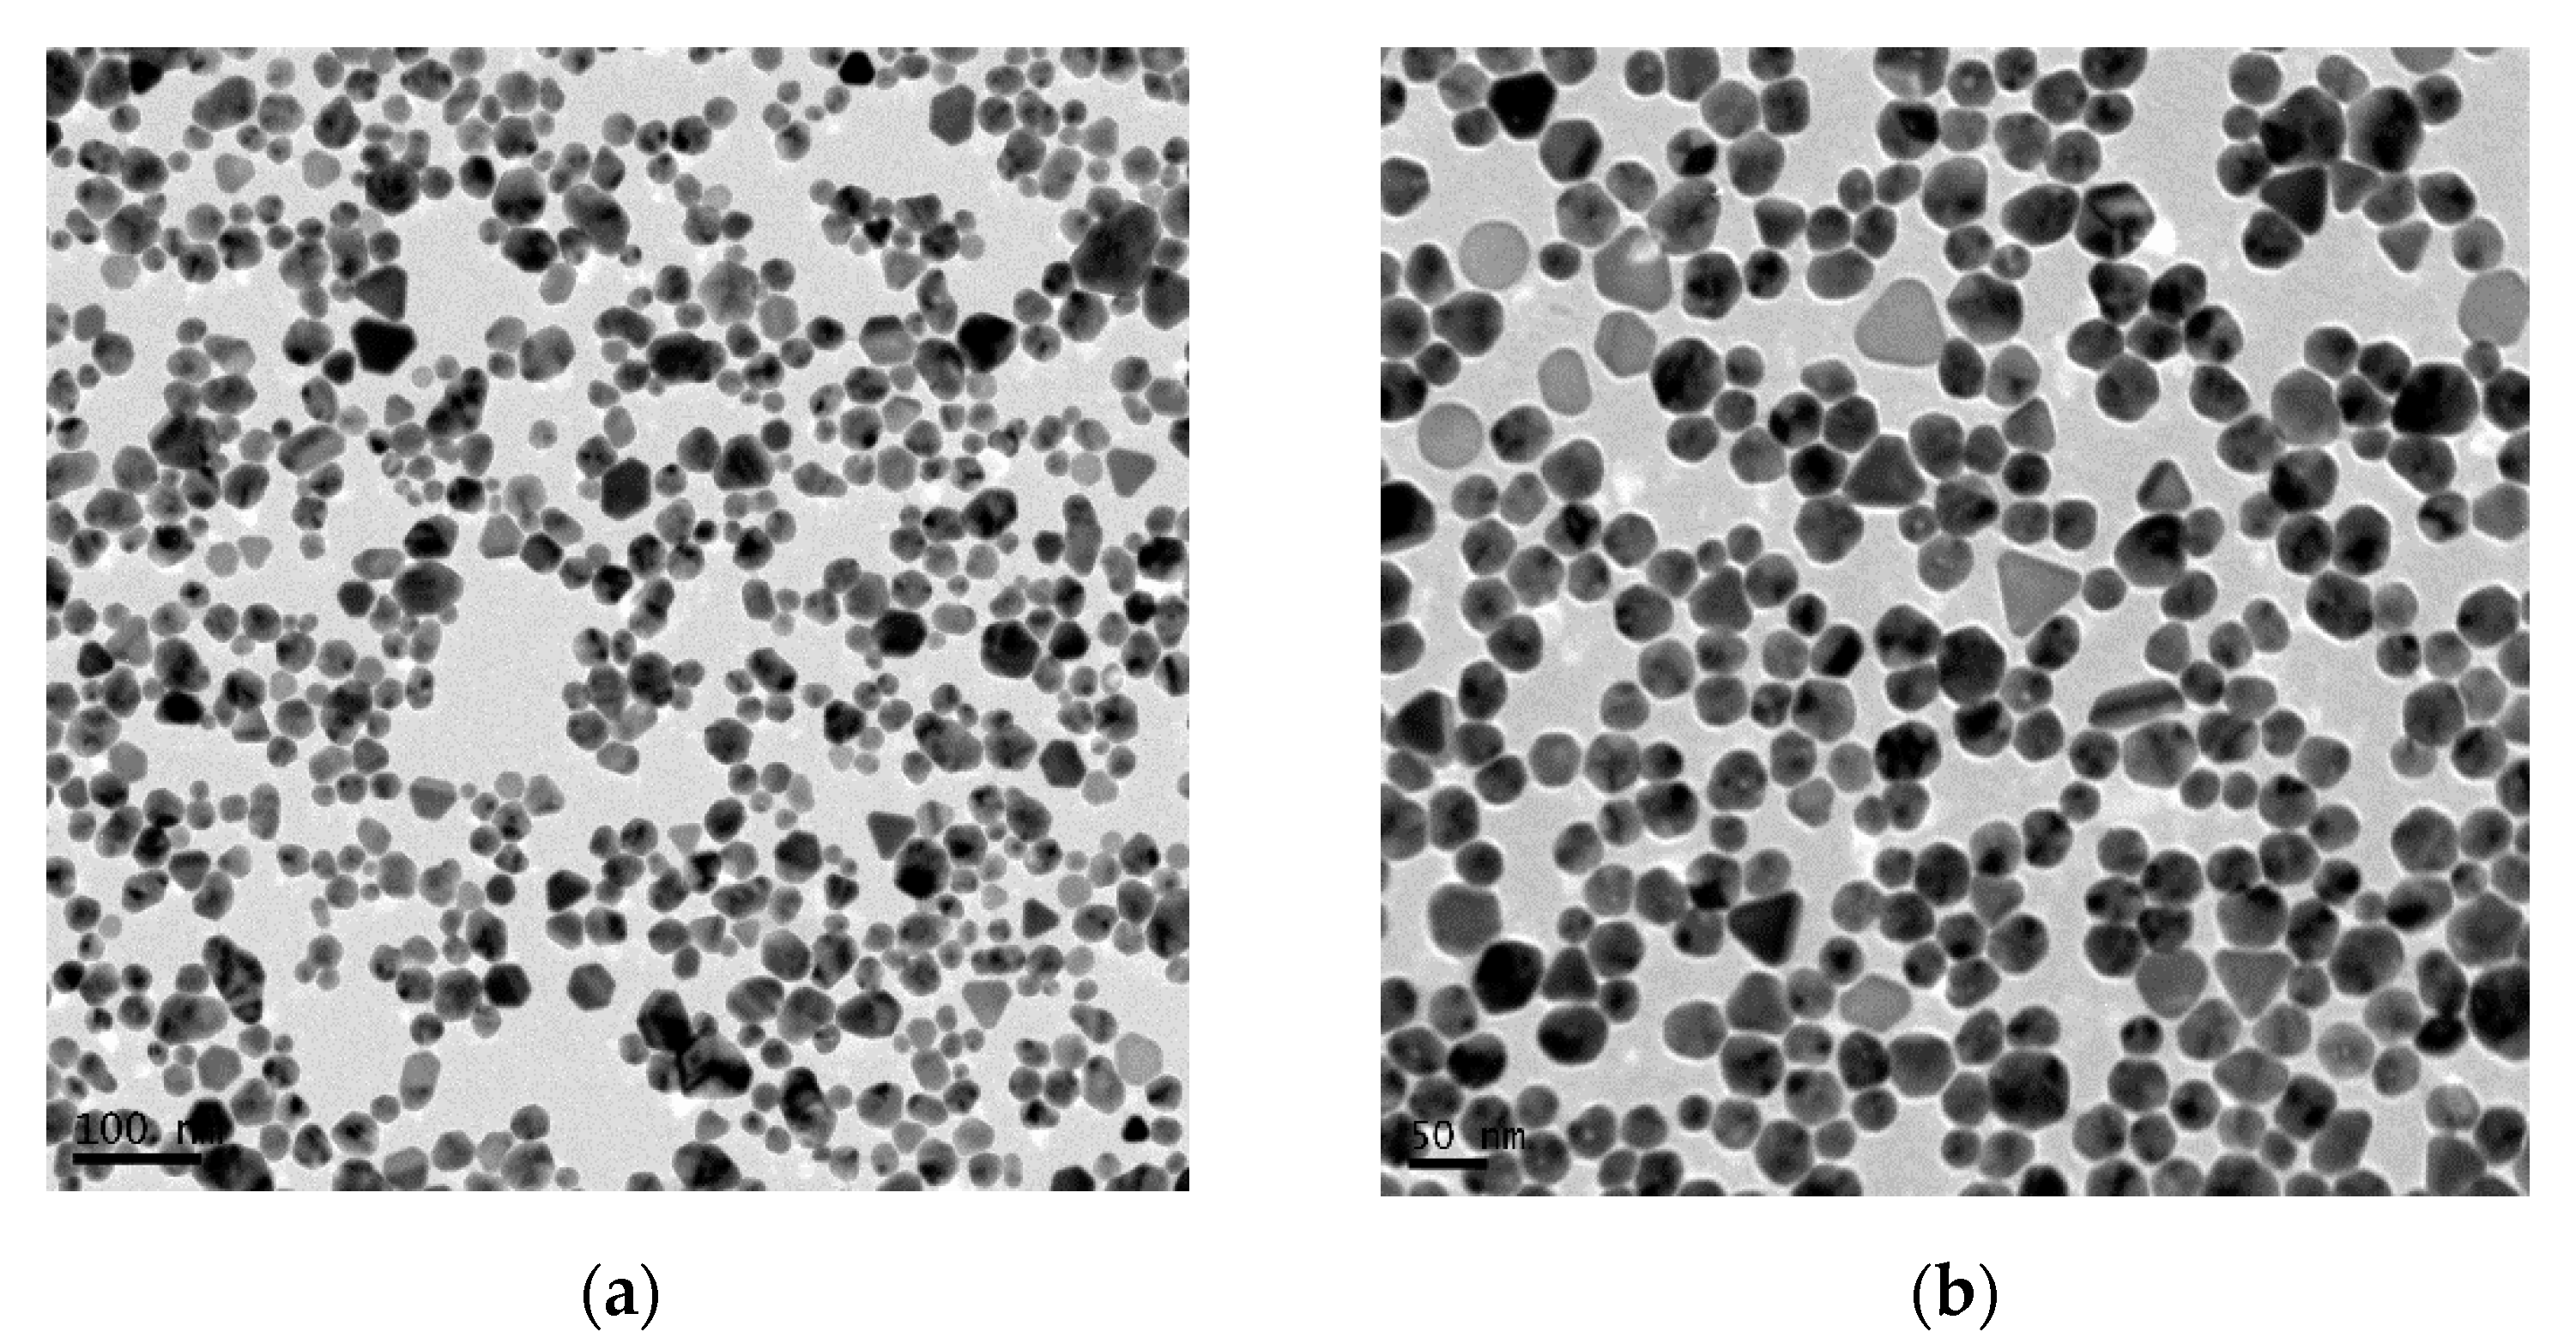
Nanomaterials 10 00019 g002 Nanomaterials 10 00019 g002

NePCM Based on Silver Dispersions in Poly(Ethylene Glycol) as a Stable Solution for Thermal Storage
Abstract
1. Introduction
2. Materials and Methods
2.1. Materials
2.2. Nanoparticle and Base Fluid Characterization
2.3. Thermal and Temporal Stability
2.4. Thermophysical Characterization
3. Results and Discussion
3.1. Phase Change Characterization
3.2. Isobaric Heat Capacity
3.3. Thermal Conductivity
3.4. Density
3.5. Thermal Diffusivity
3.6. Viscosity
3.7. Surface Tension
4. Conclusions
Author Contributions
Funding
Acknowledgments
Conflicts of Interest
References
- Xu, Y.; Ren, Q.; Zheng, Z.-J.; He, Y.-L. Evaluation and optimization of melting performance for a latent heat thermal energy storage unit partially filled with porous media. Appl. Energy 2017, 193, 84–95. [Google Scholar] [CrossRef]
- de Gracia, A.; Cabeza, L.F. Phase change materials and thermal energy storage for buildings. Energy Build. 2015, 103, 414–419. [Google Scholar] [CrossRef]
- Sharma, A.; Tyagi, V.V.; Chen, C.; Buddhi, D. Review on thermal energy storage with phase change materials and applications. Renew. Sust. Energy Rev. 2009, 13, 318–345. [Google Scholar] [CrossRef]
- Colla, L.; Ercole, D.; Fedele, L.; Mancin, S.; Manca, O.; Bobbo, S. Nano-phase change materials for electronics cooling applications. J. Heat Transf. 2017, 139, 052406. [Google Scholar] [CrossRef]
- Pandey, A.K.; Hossain, M.S.; Tyagi, V.V.; Abd Rahim, N.; Selvaraj, J.A.L.; Sari, A. Novel approaches and recent developments on potential applications of phase change materials in solar energy. Renew. Sustain. Energy Rev. 2018, 82, 281–323. [Google Scholar] [CrossRef]
- Oró, E.; Miró, L.; Farid, M.M.; Cabeza, L.F. Thermal analysis of a low temperature storage unit using phase change materials without refrigeration system. Int. J. Refrig. 2012, 35, 1709–1714. [Google Scholar] [CrossRef]
- Oró, E.; Miró, L.; Farid, M.M.; Cabeza, L.F. Improving thermal performance of freezers using phase change materials. Int. J. Refrig. 2012, 35, 984–991. [Google Scholar] [CrossRef]
- Veerakumar, C.; Sreekumar, A. Phase change material based cold thermal energy storage: Materials, techniques and applications–a review. Int. J. Refrig. 2016, 67, 271–289. [Google Scholar] [CrossRef]
- Yusufoglu, Y.; Apaydin, T.; Yilmaz, S.; Paksoy, H.O. Improving performance of household refrigerators by incorporating phase change materials. Int. J. Refrig. 2015, 57, 173–185. [Google Scholar] [CrossRef]
- Sarbu, I.; Sebarchievici, C. Solar Heating and Cooling Systems: Fundamentals, Experiments and Applications; Academic Press.: London, UK, 2016. [Google Scholar]
- Qian, T.; Li, J.; Ma, H.; Yang, J. Adjustable thermal property of polyethylene glycol/diatomite shape-stabilized composite phase change material. Polym. Compos. 2016, 37, 854–860. [Google Scholar] [CrossRef]
- Pielichowska, K.; Pielichowski, K. Phase change materials for thermal energy storage. Prog. Mater. Sci. 2014, 65, 67–123. [Google Scholar] [CrossRef]
- Pielichowski, K.; Flejtuch, K. Differential scanning calorimetry studies on poly (ethylene glycol) with different molecular weights for thermal energy storage materials. Polym. Advan. Technol. 2002, 13, 690–696. [Google Scholar] [CrossRef]
- Cabeza, L.F.; Castell, A.; Barreneche, C.; de Gracia, A.; Fernández, A.I. Materials used as PCM in thermal energy storage in buildings: A review. Renew. Sustain. Energy Rev. 2011, 15, 1675–1695. [Google Scholar] [CrossRef]
- Babapoor, A.; Karimi, G.; Khorram, M. Fabrication and characterization of nanofiber-nanoparticle-composites with phase change materials by electrospinning. Appl. Therm. Eng. 2016, 99, 1225–1235. [Google Scholar] [CrossRef]
- Khodadadi, J.; Hosseinizadeh, S. Nanoparticle-enhanced phase change materials (NePCM) with great potential for improved thermal energy storage. Int. Commun. Heat Mass 2007, 34, 534–543. [Google Scholar] [CrossRef]
- Nazir, H.; Batool, M.; Bolivar Osorio, F.J.; Isaza-Ruiz, M.; Xu, X.; Vignarooban, K.; Phelan, P.; Inamuddin; Kannan, A.M. Recent developments in phase change materials for energy storage applications: A review. Int. J. Heat Mass Tran. 2019, 129, 491–523. [Google Scholar] [CrossRef]
- Zhao, C.Y.; Lu, W.; Tian, Y. Heat transfer enhancement for thermal energy storage using metal foams embedded within phase change materials (PCMs). Sol. Energy 2010, 84, 1402–1412. [Google Scholar] [CrossRef]
- Liu, Y.; Li, X.; Hu, P.; Hu, G. Study on the supercooling degree and nucleation behavior of water-based graphene oxide nanofluids pcm. Int. J. Refrig. 2015, 50, 80–86. [Google Scholar] [CrossRef]
- Pisello, A.L.; Paolini, R.; Diamanti, M.V.; Fortunati, E.; Castaldo, V.L.; Torre, L. Nanotech-based cool materials for building energy efficiency. In Nano and Biotech Based Materials for Energy Building Efficiency; Springer: Berlin/Heidelberg, Germany, 2016; pp. 245–278. [Google Scholar]
- Shamshirgaran, S.R.; Khalaji, A.M.; Viswanatha, S.K. Application of nanomaterials in solar thermal energy storage. Heat Mass Transf. 2018, 54, 1555–1577. [Google Scholar] [CrossRef]
- Murshed, S.S.; Estellé, P. A state of the art review on viscosity of nanofluids. Renew. Sust. Energy Rev. 2017, 76, 1134–1152. [Google Scholar] [CrossRef]
- Vallejo, J.P.; Żyła, G.; Fernández-Seara, J.; Lugo, L. Rheological behaviour of functionalized graphene nanoplatelet nanofluids based on water and propylene glycol:water mixtures. Int. Commun. Heat Mass 2018, 99, 43–53. [Google Scholar] [CrossRef]
- Żyła, G.; Fal, J.; Estellé, P. Thermophysical and dielectric profiles of ethylene glycol based titanium nitride (TiN–EG) nanofluids with various size of particles. Int. J. Heat Mass Tran. 2017, 113, 1189–1199. [Google Scholar] [CrossRef]
- Żyła, G.; Vallejo, J.P.; Lugo, L. Isobaric heat capacity and density of ethylene glycol based nanofluids containing various nitride nanoparticle types: An experimental study. J. Mol. Liq. 2018, 261, 530–539. [Google Scholar] [CrossRef]
- Cabaleiro, D.; Gracia-Fernández, C.; Legido, J.; Lugo, L. Specific heat of metal oxide nanofluids at high concentrations for heat transfer. Int. J. Heat Mass Tran. 2015, 88, 872–879. [Google Scholar] [CrossRef]
- Estellé, P.; Cabaleiro, D.; Żyła, G.; Lugo, L.; Murshed, S.S. Current trends in surface tension and wetting behavior of nanofluids. Renew. Sustain. Energy Rev. 2018, 94, 931–944. [Google Scholar] [CrossRef]
- Savino, R.; Di Paola, R.; Cecere, A.; Fortezza, R. Self-rewetting heat transfer fluids and nanobrines for space heat pipes. Acta Astronaut. 2010, 67, 1030–1037. [Google Scholar] [CrossRef]
- Singh, R.; Sadeghi, S.; Shabani, B. Thermal conductivity enhancement of phase change materials for low-temperature thermal energy storage applications. Energies 2019, 12, 75. [Google Scholar] [CrossRef]
- Marcos, M.; Cabaleiro, D.; Guimarey, M.; Comuñas, M.; Fedele, L.; Fernández, J.; Lugo, L. PEG400-based phase change materials nano-enhanced with functionalized graphene nanoplatelets. Nanomaterials 2017, 8, 16. [Google Scholar] [CrossRef]
- Yang, J.; Tang, L.-S.; Bao, R.-Y.; Bai, L.; Liu, Z.-Y.; Yang, W.; Xie, B.-H.; Yang, M.-B. Largely enhanced thermal conductivity of poly (ethylene glycol)/boron nitride composite phase change materials for solar-thermal-electric energy conversion and storage with very low content of graphene nanoplatelets. Chem. Eng. J. 2017, 315, 481–490. [Google Scholar] [CrossRef]
- Marcos, M.A.; Podolsky, N.E.; Cabaleiro, D.; Lugo, L.; Zakharov, A.O.; Postnov, V.N.; Charykov, N.A.; Ageev, S.V.; Semenov, K.N. MWCNT in PEG-400 nanofluids for thermal applications: A chemical, physical and thermal approach. J. Mol. Liq. 2019, 294, 111616. [Google Scholar] [CrossRef]
- Anghel, E.M.; Pavel, P.M.; Constantinescu, M.; Petrescu, S.; Atkinson, I.; Buixaderas, E. Thermal transfer performance of a spherical encapsulated PEG6000-based composite for thermal energy storage. Appl. Energy 2017, 208, 1222–1231. [Google Scholar] [CrossRef]
- Tang, B.; Cui, J.; Wang, Y.; Jia, C.; Zhang, S. Facile synthesis and performances of PEG/SiO2 composite form-stable phase change materials. Sol. Energy 2013, 97, 484–492. [Google Scholar] [CrossRef]
- Tang, B.; Qiu, M.; Zhang, S. Thermal conductivity enhancement of PEG/SiO2 composite PCM by in situ Cu doping. Sol. Energy Mat. Sol. Cells 2012, 105, 242–248. [Google Scholar] [CrossRef]
- Tang, B.; Wu, C.; Qiu, M.; Zhang, X.; Zhang, S. PEG/SiO2–Al2O3 hybrid form-stable phase change materials with enhanced thermal conductivity. Mater. Chem. Phys. 2014, 144, 162–167. [Google Scholar] [CrossRef]
- Feng, L.; Zheng, J.; Yang, H.; Guo, Y.; Li, W.; Li, X. Preparation and characterization of polyethylene glycol/active carbon composites as shape-stabilized phase change materials. Sol. Energy Mat. Sol. Cells 2011, 95, 644–650. [Google Scholar] [CrossRef]
- Yang, H.; Feng, L.; Wang, C.; Zhao, W.; Li, X. Confinement effect of SiO2 framework on phase change of peg in shape-stabilized PEG/SiO2 composites. Eur. Polym. J. 2012, 48, 803–810. [Google Scholar] [CrossRef]
- Li, J.; He, L.; Liu, T.; Cao, X.; Zhu, H. Preparation and characterization of PEG/SiO2 composites as shape-stabilized phase change materials for thermal energy storage. Sol. Energy Mat. Sol. Cells 2013, 118, 48–53. [Google Scholar] [CrossRef]
- Tang, B.; Wang, Y.; Qiu, M.; Zhang, S. A full-band sunlight-driven carbon nanotube/PEG/SiO2 composites for solar energy storage. Sol. Energy Mat. Sol. Cells 2014, 123, 7–12. [Google Scholar] [CrossRef]
- Liu, Z.; Wei, H.; Tang, B.; Xu, S.; Shufen, Z. Novel light–driven CF/PEG/SiO2 composite phase change materials with high thermal conductivity. Sol. Energy Mat. Sol. Cells 2018, 174, 538–544. [Google Scholar] [CrossRef]
- Li, X.F.; Zhu, D.S.; Wang, X.J.; Wang, N.; Gao, J.W.; Li, H. Thermal conductivity enhancement dependent ph and chemical surfactant for Cu-H2O nanofluids. Thermochim. Acta 2008, 469, 98–103. [Google Scholar] [CrossRef]
- Patel, H.E.; Das, S.K.; Sundararajan, T.; Sreekumaran, N.A.; George, B.; Pradeep, T. Thermal conductivities of naked and monolayer protected metal nanoparticle based nanofluids: Manifestation of anomalous enhancement and chemical effects. Appl. Phys. Lett. 2003, 83, 2931–2933. [Google Scholar] [CrossRef]
- Yu, W.; Xie, H.; Chen, L.; Li, Y. Investigation on the thermal transport properties of ethylene glycol-based nanofluids containing copper nanoparticles. Powder Technol. 2010, 197, 218–221. [Google Scholar] [CrossRef]
- Zeng, J.L.; Sun, L.X.; Xu, F.; Tan, Z.C.; Zhang, Z.H.; Zhang, J.; Zhang, T. Study of a PCM based energy storage system containing Ag nanoparticles. J. Therm. Anal. Calorim. 2007, 87, 371–375. [Google Scholar] [CrossRef]
- Deng, Y.; Li, J.; Qian, T.; Guan, W.; Li, Y.; Yin, X. Thermal conductivity enhancement of polyethylene glycol/expanded vermiculite shape-stabilized composite phase change materials with silver nanowire for thermal energy storage. Chem. Eng. J. 2016, 295, 427–435. [Google Scholar] [CrossRef]
- Qian, T.; Li, J.; Min, X.; Guan, W.; Deng, Y.; Ning, L. Enhanced thermal conductivity of PEG/diatomite shape-stabilized phase change materials with Ag nanoparticles for thermal energy storage. J. Mater. Chem. A 2015, 3, 8526–8536. [Google Scholar] [CrossRef]
- Chen, R.-H.; Phuoc, T.X.; Martello, D. Surface tension of evaporating nanofluid droplets. Int. J. Heat Mass Tran. 2011, 54, 2459–2466. [Google Scholar] [CrossRef]
- Godson, L.; Raja, B.; Lal, D.M.; Wongwises, S. Experimental investigation on the thermal conductivity and viscosity of silver-deionized water nanofluid. Exp. Heat Transf 2010, 23, 317–332. [Google Scholar] [CrossRef]
- Lee, H.-H.; Chou, K.-S.; Huang, K.-C. Inkjet printing of nanosized silver colloids. Nanotechnology 2005, 16, 2436. [Google Scholar] [CrossRef]
- Ankireddy, K.; Vunnam, S.; Kellar, J.; Cross, W. Highly conductive short chain carboxylic acid encapsulated silver nanoparticle based inks for direct write technology applications. J. Mater. Chem. C 2013, 1, 572–579. [Google Scholar] [CrossRef]
- Parker, W.; Jenkins, R.; Butler, C.; Abbott, G. Flash method of determining thermal diffusivity, heat capacity, and thermal conductivity. J. Appl. Phys. 1961, 32, 1679–1684. [Google Scholar] [CrossRef]
- Mourdikoudis, S.; Pallares, R.M.; Thanh, N.T.K. Characterization techniques for nanoparticles: Comparison and complementarity upon studying nanoparticle properties. Nanoscale 2018, 10, 12871–12934. [Google Scholar] [CrossRef] [PubMed]
- Ghaseminezhad, S.M.; Hamedi, S.; Shojaosadati, S.A. Green synthesis of silver nanoparticles by a novel method: Comparative study of their properties. Carbohydr. Polym. 2012, 89, 467–472. [Google Scholar] [CrossRef] [PubMed]
- Huang, N.; Lim, H.; Radiman, S.; Khiew, P.; Chiu, W.; Hashim, R.; Chia, C.H. Sucrose ester micellar-mediated synthesis of Ag nanoparticles and the antibacterial properties. Colloids Surf. A Physicochem. Eng. Asp. 2010, 353, 69–76. [Google Scholar] [CrossRef]
- Tomaszewska, E.; Soliwoda, K.; Kadziola, K.; Tkacz-Szczesna, B.; Celichowski, G.; Cichomski, M.; Szmaja, W.; Grobelny, J. Detection limits of dls and UV-Vis spectroscopy in characterization of polydisperse nanoparticles colloids. J. Nanomater. 2013, 2013, 10. [Google Scholar] [CrossRef]
- Vigneshwaran, N.; Nachane, R.P.; Balasubramanya, R.H.; Varadarajan, P.V. A novel one-pot ‘green’ synthesis of stable silver nanoparticles using soluble starch. Carbohyd. Res. 2006, 341, 2012–2018. [Google Scholar] [CrossRef]
- Ottani, S.; Vitalini, D.; Comelli, F.; Castellari, C. Densities, viscosities, and refractive indices of poly(ethylene glycol) 200 and 400 + cyclic ethers at 303.15 k. J. Chem. Eng. Data 2002, 47, 1197–1204. [Google Scholar] [CrossRef]
- Ottani, S.; Vitalini, D.; Comelli, F.; Castellari, C. Densities, viscosities, and refractive indices of new mixtures of poly(ethylene glycols) + dialkyl carbonates at 313.15 k. J. Chem. Eng. Data 2004, 49, 148–154. [Google Scholar] [CrossRef]
- Fedele, L.; Colla, L.; Bobbo, S. Viscosity and thermal conductivity measurements of water-based nanofluids containing titanium oxide nanoparticles. Int. J. Refrig. 2012, 35, 1359–1366. [Google Scholar] [CrossRef]
- Colla, L.; Fedele, L.; Buschmann, M.H. Laminar mixed convection of TiO2–water nanofluid in horizontal uniformly heated pipe flow. Int. J. Therm. Sci. 2015, 97, 26–40. [Google Scholar] [CrossRef]
- Fedele, L.; Colla, L.; Bobbo, S.; Barison, S.; Agresti, F. Experimental stability analysis of different water-based nanofluids. Nanoscale Res. Lett. 2011, 6, 300. [Google Scholar] [CrossRef]
- Cabaleiro, D.; Gracia-Fernández, C.; Lugo, L. (solid+liquid) phase equilibria and heat capacity of (diphenyl ether+biphenyl) mixtures used as thermal energy storage materials. J. Chem. Thermodyn. 2014, 74, 43–50. [Google Scholar] [CrossRef]
- Rodríguez-Pérez, M.; Reglero, J.; Lehmhus, D.; Wichmann, M.; De Saja, J.; Fernández, A. The Transient Plane Source Technique (TPS) to Measure Thermal Conductivity and its Potential as A Tool to Detect In-Homogeneities in Metal Foams. In Proceedings of the International Conference “Advanced Metallic Materials”, Smolenice, Slovakia, 5–7 November 2003; pp. 253–257. [Google Scholar]
- Lemmon, E.; Huber, M.; McLinden, M. NIST Standard Reference Database 23, Reference Fluid Thermodynamic and Transport Properties (Refprop), version 9.0; National Institute of Standards and Technology: Gaithersburg, MD, USA, 2010. [Google Scholar]
- Bobbo, S.; Fedele, L.; Benetti, A.; Colla, L.; Fabrizio, M.; Pagura, C.; Barison, S. Viscosity of water based SWCNH and TiO2 nanofluids. Exp. Therm. Fluid Sci. 2012, 36, 65–71. [Google Scholar] [CrossRef]
- Żyła, G.; Vallejo, J.P.; Fal, J.; Lugo, L. Nanodiamonds—Ethylene glycol nanofluids: Experimental investigation of fundamental physical properties. Int. J. Heat Mass Tran. 2018, 121, 1201–1213. [Google Scholar] [CrossRef]
- Berrada, N.; Hamze, S.; Desforges, A.; Ghanbaja, J.; Gleize, J.; Mare, T.; Vigolo, B.; Estellé, P. Surface tension of functionalized mwcnt-based nanofluids in water and commercial propylene-glycol mixture. J. Mol. Liq. 2019, 293, 111473. [Google Scholar] [CrossRef]
- Gómez-Villarejo, R.; Aguilar, T.; Hamze, S.; Estellé, P.; Navas, J. Experimental analysis of water-based nanofluids using boron nitride nanotubes with improved thermal properties. J. Mol. Liq. 2019, 277, 93–103. [Google Scholar] [CrossRef]
- Francesconi, R.; Bigi, A.; Rubini, K.; Comelli, F. Molar heat capacities, densities, viscosities, and refractive indices of poly (ethylene glycols)+ 2-methyltetrahydrofuran at (293.15, 303.15, and 313.15) K. J. Chem. Eng. Data 2007, 52, 2020–2025. [Google Scholar] [CrossRef]
- Touloukian, Y.; Buyco, E. Specific heat-metallic elements and alloys. In Thermophysical Properties of Matter; The TPRC Data Series: West Lafayette, IN, USA, 1971; Volume 4. [Google Scholar]
- Zhou, S.-Q.; Ni, R. Measurement of the specific heat capacity of water-based Al2O3 nanofluid. Appl. Phys. Lett. 2008, 92, 093123. [Google Scholar] [CrossRef]
- O’Hanley, H.; Buongiorno, J.; McKrell, T.; Hu, L.-W. Measurement and model validation of nanofluid specific heat capacity with differential scanning calorimetry. Adv. Mech. Eng. 2012, 4, 181079. [Google Scholar] [CrossRef]
- Maxwell, J.C. A Treatise on Electricity and Magnetism; Clarendon Press: Oxford, UK, 1873; Volume 1. [Google Scholar]
- Azmi, W.H.; Sharma, K.V.; Mamat, R.; Najafi, G.; Mohamad, M.S. The enhancement of effective thermal conductivity and effective dynamic viscosity of nanofluids—A review. Renew. Sust. Energy Rev. 2016, 53, 1046–1058. [Google Scholar] [CrossRef]
- Beck, M.P.; Yuan, Y.; Warrier, P.; Teja, A.S. The effect of particle size on the thermal conductivity of alumina nanofluids. J. Nanopart. Res. 2009, 11, 1129–1136. [Google Scholar] [CrossRef]
- Timofeeva, E.V.; Gavrilov, A.N.; McCloskey, J.M.; Tolmachev, Y.V.; Sprunt, S.; Lopatina, L.M.; Selinger, J.V. Thermal conductivity and particle agglomeration in alumina nanofluids: Experiment and theory. Phys. Rev. E 2007, 76, 061203. [Google Scholar] [CrossRef]
- Frank, M.; Drikakis, D. Solid-like heat transfer in confined liquids. Microfluid Nanofluidics 2017, 21, 148. [Google Scholar] [CrossRef] [PubMed]
- Frank, M.; Drikakis, D.; Asproulis, N. Thermal conductivity of nanofluid in nanochannels. Microfluid. Nanofluidics 2015, 19, 1011–1017. [Google Scholar] [CrossRef]
- Murshed, S.; Leong, K.; Yang, C. Investigations of thermal conductivity and viscosity of nanofluids. Int. J. Therm. Sci. 2008, 47, 560–568. [Google Scholar] [CrossRef]
- Frank, M.; Drikakis, D. Thermodynamics at solid–liquid interfaces. Entropy 2018, 20, 362. [Google Scholar] [CrossRef]
- Halté, V.; Bigot, J.-Y.; Palpant, B.; Broyer, M.; Prével, B.; Pérez, A. Size dependence of the energy relaxation in silver nanoparticles embedded in dielectric matrices. Appl. Phys. Lett. 1999, 75, 3799–3801. [Google Scholar] [CrossRef]
- Özerinç, S.; Kakaç, S.; Yazıcıoğlu, A.G. Enhanced thermal conductivity of nanofluids: A state-of-the-art review. Microfluid. Nanofluid. 2010, 8, 145–170. [Google Scholar] [CrossRef]
- Warrier, P.; Teja, A. Effect of particle size on the thermal conductivity of nanofluids containing metallic nanoparticles. Nanoscale Res. Lett. 2011, 6, 247. [Google Scholar] [CrossRef]
- Nath, P.; Chopra, K.L. Thermal conductivity of copper films. Thin Solid Film. 1974, 20, 53–62. [Google Scholar] [CrossRef]
- Trivedi, S.; Bhanot, C.; Pandey, S. Densities of {poly(ethylene glycol)+water} over the temperature range (283.15 to 363.15) K. J. Chem. Thermodyn. 2010, 42, 1367–1371. [Google Scholar] [CrossRef]
- Afzal, W.; Mohammadi, A.H.; Richon, D. Volumetric properties of mono-, di-, tri-, and polyethylene glycol aqueous solutions from (273.15 to 363.15) K: Experimental measurements and correlations. J. Chem. Eng. Data 2009, 54, 1254–1261. [Google Scholar] [CrossRef]
- Han, F.; Zhang, J.; Chen, G.; Wei, X. Density, viscosity, and excess properties for aqueous poly(ethylene glycol) solutions from (298.15 to 323.15) k. J. Chem. Eng. Data 2008, 53, 2598–2601. [Google Scholar] [CrossRef]
- Nakhjavani, M.; Nikkhah, V.; Sarafraz, M.M.; Shoja, S.; Sarafraz, M. Green synthesis of silver nanoparticles using green tea leaves: Experimental study on the morphological, rheological and antibacterial behaviour. Heat Mass Transf. 2017, 53, 3201–3209. [Google Scholar] [CrossRef]
- Bahiraei, M.; Heshmatian, S. Efficacy of a novel liquid block working with a nanofluid containing graphene nanoplatelets decorated with silver nanoparticles compared with conventional CPU coolers. Appl. Therm. Eng. 2017, 127, 1233–1245. [Google Scholar] [CrossRef]
- Yarmand, H.; Gharehkhani, S.; Ahmadi, G.; Shirazi, S.F.S.; Baradaran, S.; Montazer, E.; Zubir, M.N.M.; Alehashem, M.S.; Kazi, S.; Dahari, M. Graphene nanoplatelets–silver hybrid nanofluids for enhanced heat transfer. Energy Convers. Manag. 2015, 100, 419–428. [Google Scholar] [CrossRef]
- Nguyen, T.T.T.; Park, J.S. Fabrication of electrospun nonwoven mats of polyvinylidene fluoride/polyethylene glycol/fumed silica for use as energy storage materials. J. Appl. Polym. Sci. 2011, 121, 3596–3603. [Google Scholar] [CrossRef]
- Chen, H.; Ding, Y.; Tan, C. Rheological behaviour of nanofluids. New J. Phys. 2007, 9, 367. [Google Scholar] [CrossRef]
- Tamjid, E.; Guenther, B.H. Rheology and colloidal structure of silver nanoparticles dispersed in diethylene glycol. Powder Technol. 2010, 197, 49–53. [Google Scholar] [CrossRef]
- Angell, C.; MacFarlane, D.; Oguni, M. The kauzmann paradox, metastable liquids, and ideal glasses. Ann. N. Y. Acad. Sci 1986, 484, 241–247. [Google Scholar] [CrossRef]
- Paredes, X.; Pensado, A.S.; Comuñas, M.a.J.; Fernández, J. How pressure affects the dynamic viscosities of two poly (propylene glycol) dimethyl ether lubricants. J. Chem. Eng. Data 2010, 55, 4088–4094. [Google Scholar] [CrossRef]
- Siongco, K.R.; Leron, R.B.; Li, M.-H. Densities, refractive indices, and viscosities of n,n-diethylethanol ammonium chloride–glycerol or –ethylene glycol deep eutectic solvents and their aqueous solutions. J. Chem. Thermodyn. 2013, 65, 65–72. [Google Scholar] [CrossRef]
- Hodge, I.M. Strong and fragile liquids—A brief critique. J. Non-Cryst. Solids 1996, 202, 164–172. [Google Scholar] [CrossRef]
- Zadeh, A.D.; Toghraie, D. Experimental investigation for developing a new model for the dynamic viscosity of silver/ethylene glycol nanofluid at different temperatures and solid volume fractions. J. Therm. Anal. Calorim. 2018, 131, 1449–1461. [Google Scholar] [CrossRef]
- Einstein, A. Eine neue bestimmung der moleküldimensionen. Ann. Phys. 1906, 324, 289–306. [Google Scholar] [CrossRef]
- Chow, T. Viscosities of concentrated dispersions. Phys. Rev. E 1993, 48, 1977. [Google Scholar] [CrossRef]
- Pal, R.; Rhodes, E. Viscosity/concentration relationships for emulsions. J. Rheol. 1989, 33, 1021–1045. [Google Scholar] [CrossRef]
- Fu, D.; Du, L.; Wang, H. Experiment and model for the surface tension of MEA-PEG400 and DEA-PEG400 aqueous solutions. J. Chem. Thermodyn. 2014, 69, 132–136. [Google Scholar] [CrossRef]

| Base Fluid (0 wt%) | 0.10 wt% | 0.50 wt% | 1.1 wt% | |
|---|---|---|---|---|
| η0/mPa·s | 0.0659 | 0.0672 | 0.0239 | 0.0246 |
| D | 6.37 | 6.37 | 9.93 | 9.92 |
| T0/K | 158.19 | 158.08 | 135.41 | 135.57 |
| s/mPa·s | 1.4 | 1.3 | 2.4 | 2.1 |
| AAD% | 1.2% | 1.1% | 2.2% | 2.0% |
© 2019 by the authors. Licensee MDPI, Basel, Switzerland. This article is an open access article distributed under the terms and conditions of the Creative Commons Attribution (CC BY) license (http://creativecommons.org/licenses/by/4.0/).
Share and Cite
Marcos, M.A.; Cabaleiro, D.; Hamze, S.; Fedele, L.; Bobbo, S.; Estellé, P.; Lugo, L. NePCM Based on Silver Dispersions in Poly(Ethylene Glycol) as a Stable Solution for Thermal Storage. Nanomaterials 2020, 10, 19. https://doi.org/10.3390/nano10010019
Marcos MA, Cabaleiro D, Hamze S, Fedele L, Bobbo S, Estellé P, Lugo L. NePCM Based on Silver Dispersions in Poly(Ethylene Glycol) as a Stable Solution for Thermal Storage. Nanomaterials. 2020; 10(1):19. https://doi.org/10.3390/nano10010019
Chicago/Turabian StyleMarcos, Marco A., David Cabaleiro, Samah Hamze, Laura Fedele, Sergio Bobbo, Patrice Estellé, and Luis Lugo. 2020. "NePCM Based on Silver Dispersions in Poly(Ethylene Glycol) as a Stable Solution for Thermal Storage" Nanomaterials 10, no. 1: 19. https://doi.org/10.3390/nano10010019
APA StyleMarcos, M. A., Cabaleiro, D., Hamze, S., Fedele, L., Bobbo, S., Estellé, P., & Lugo, L. (2020). NePCM Based on Silver Dispersions in Poly(Ethylene Glycol) as a Stable Solution for Thermal Storage. Nanomaterials, 10(1), 19. https://doi.org/10.3390/nano10010019









